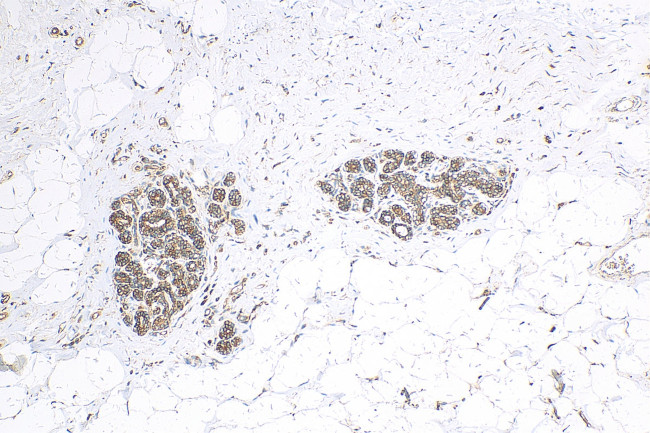
ABCB6 Antibody in Immunohistochemistry (Paraffin) (IHC (P))

Search
Proteintech
ABCB6 Polyclonal Antibody
{{$productOrderCtrl.translations['antibody.pdp.commerceCard.promotion.promotions']}}
{{$productOrderCtrl.translations['antibody.pdp.commerceCard.promotion.viewpromo']}}
{{$productOrderCtrl.translations['antibody.pdp.commerceCard.promotion.promocode']}}: {{promo.promoCode}} {{promo.promoTitle}} {{promo.promoDescription}}. {{$productOrderCtrl.translations['antibody.pdp.commerceCard.promotion.learnmore']}}
产品信息
14996-1-AP
种属反应
宿主/亚型
分类
类型
抗原
偶联物
形式
浓度
规格
纯化类型
保存液
内含物
保存条件
运输条件
产品详细信息
Immunogen sequence: TNFIDMENM FDLLKEETEV KDLPGAGPLR FQKGRIEFEN VHFSYADGRE TLQDVSFTVM PGQTLALVGP SGAGKSTILR LLFRFYDISS GCIRIDGQDI SQVTQASLRS HIGVVPQDTV LFNDTIADNI RYGRVTAGND EVEAAAQAAG IHDAIMAFPE GYRTQVGERG LKLSGGEKQR VAIARTILKA PGIILLDEAT SALDTSNERA IQASLAKVCA NRTTIVVAHR LSTVVNADQI LVIKDGCIVE RGRHEALLSR GGVYADMWQL QQGQEETSED TKPQTMER (556-842 aa encoded by BC000559)
靶标信息
The membrane-associated protein encoded by this gene is a member of the superfamily of ATP-binding cassette transporters. ABC proteins transport various molecules across extra- and intra-cellular membranes. ABC genes are divided into seven distinct subfamilies. This protein is a member of the MDR/TAP subfamily. Members of the MDR/TAP subfamily are involved in multidrug resistance as well as antigen presentation. This half-transporter likely plays a role in mitochondrial function. Localized to 2q26, this gene is considered a candidate gene for lethal neonatal metabolic syndrome, a disorder of mitochondrial function.
仅用于科研。不用于诊断过程。未经明确授权不得转售。
篇参考文献 (0)
生物信息学
蛋白别名: ABC; ABC-type heme transporter ABCB6; ATP binding cassette subfamily B member 6 (Langereis blood group); ATP-binding cassette half-transporter; ATP-binding cassette sub-family B member 6; ATP-binding cassette sub-family B member 6, mitochondrial; ATP-binding cassette, sub-family B (MDR/TAP), member 6; ATP-binding cassette, sub-family B (MDR/TAP), member 6 (Langereis blood group); EST45597; FLJ22414; Mitochondrial ABC transporter 3; Mt-ABC transporter 3; P-glycoprotein-related protein; Ubiquitously-expressed mammalian ABC half transporter; unnamed protein product
基因别名: 1200005B17Rik; ABC; ABCB6; LAN; MTABC3; PRP; UMAT
UniProt ID: (Human) Q9NP58, (Rat) O70595, (Mouse) Q9DC29
Entrez Gene ID: (Human) 10058, (Rat) 140669, (Mouse) 74104